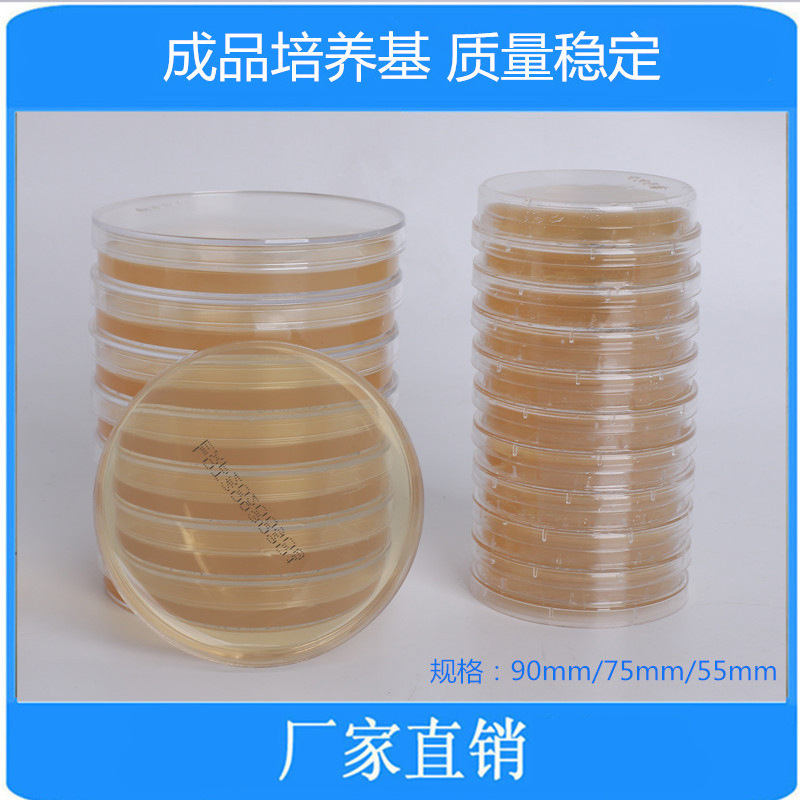
厂家直销 斜面5ml酸性改良罗/氏培养基

1688工业品为您提供在线免费查询更多化学试剂详细参数、实时报价、规格一览表。更多关于化学试剂多少钱一千克/化学试剂报价明细/化学试剂规格型号价格表/化学试剂批发市场价格/化学试剂官方报价等咨询,尽在1688工业品。询底价>
为你找到生化试剂相关产品

D10228-25mgXTT钠盐111072-31-290%仅限科研使用
北京
在线询价

透明质酸钠(分子量2500-6000) 98%,1g/5g/25g,CAS:9067-32-7
北京
在线询价

200ml硫代硫酸盐柠檬酸盐胆盐蔗糖(TCBS)琼脂 厂家直销
安徽马鞍山
在线询价

重组牛肠激酶 CAS:9014-74-8 实验科研用试剂 百克赛斯生物
河北保定
在线询价

大量现货供应分析纯 碘化钠 7681-82-5
江苏苏州
在线询价
厂家直销 斜面5ml酸性改良罗/氏培养基
安徽马鞍山
在线询价

磷酸三(2-氯丙基)酯13674-84-598%D16071-100gOKA禁止人用
北京
在线询价

小鼠白介素13受体α2(IL13Rα2)ELISA检测试剂盒
广东深圳
在线询价

紫草酸/28831-65-4/源叶 B21683/Lithospermic acid/HPLC≥98% 标
上海
在线询价

胆淄醇酯酶/胆固醇酯酶≥10U/mg 科研实验试剂CAS:9026-00-0
安徽合肥
在线询价

科研试剂 活性红X-3B/Reactive Red X-3B 级别:BS 现货 可开发票
江苏南京
在线询价
![PBS磷酸盐粉剂缓冲液 0.01mol/L pH7.2-7.4 [PH1403 PHYGENE]](https://cbu01.alicdn.com/img/ibank/O1CN01vE3uh81gCbLXOeuR3_!!2210452914106-0-cib.jpg)
PBS磷酸盐粉剂缓冲液 0.01mol/L pH7.2-7.4 [PH1403 PHYGENE]
福建福州
在线询价
查看更多产品及报价
100+生化试剂相关产品等你解锁
在线寻源3000行家正在找货
免费询价,源头正品,上1688工业品,全国的工业正品交易平台





